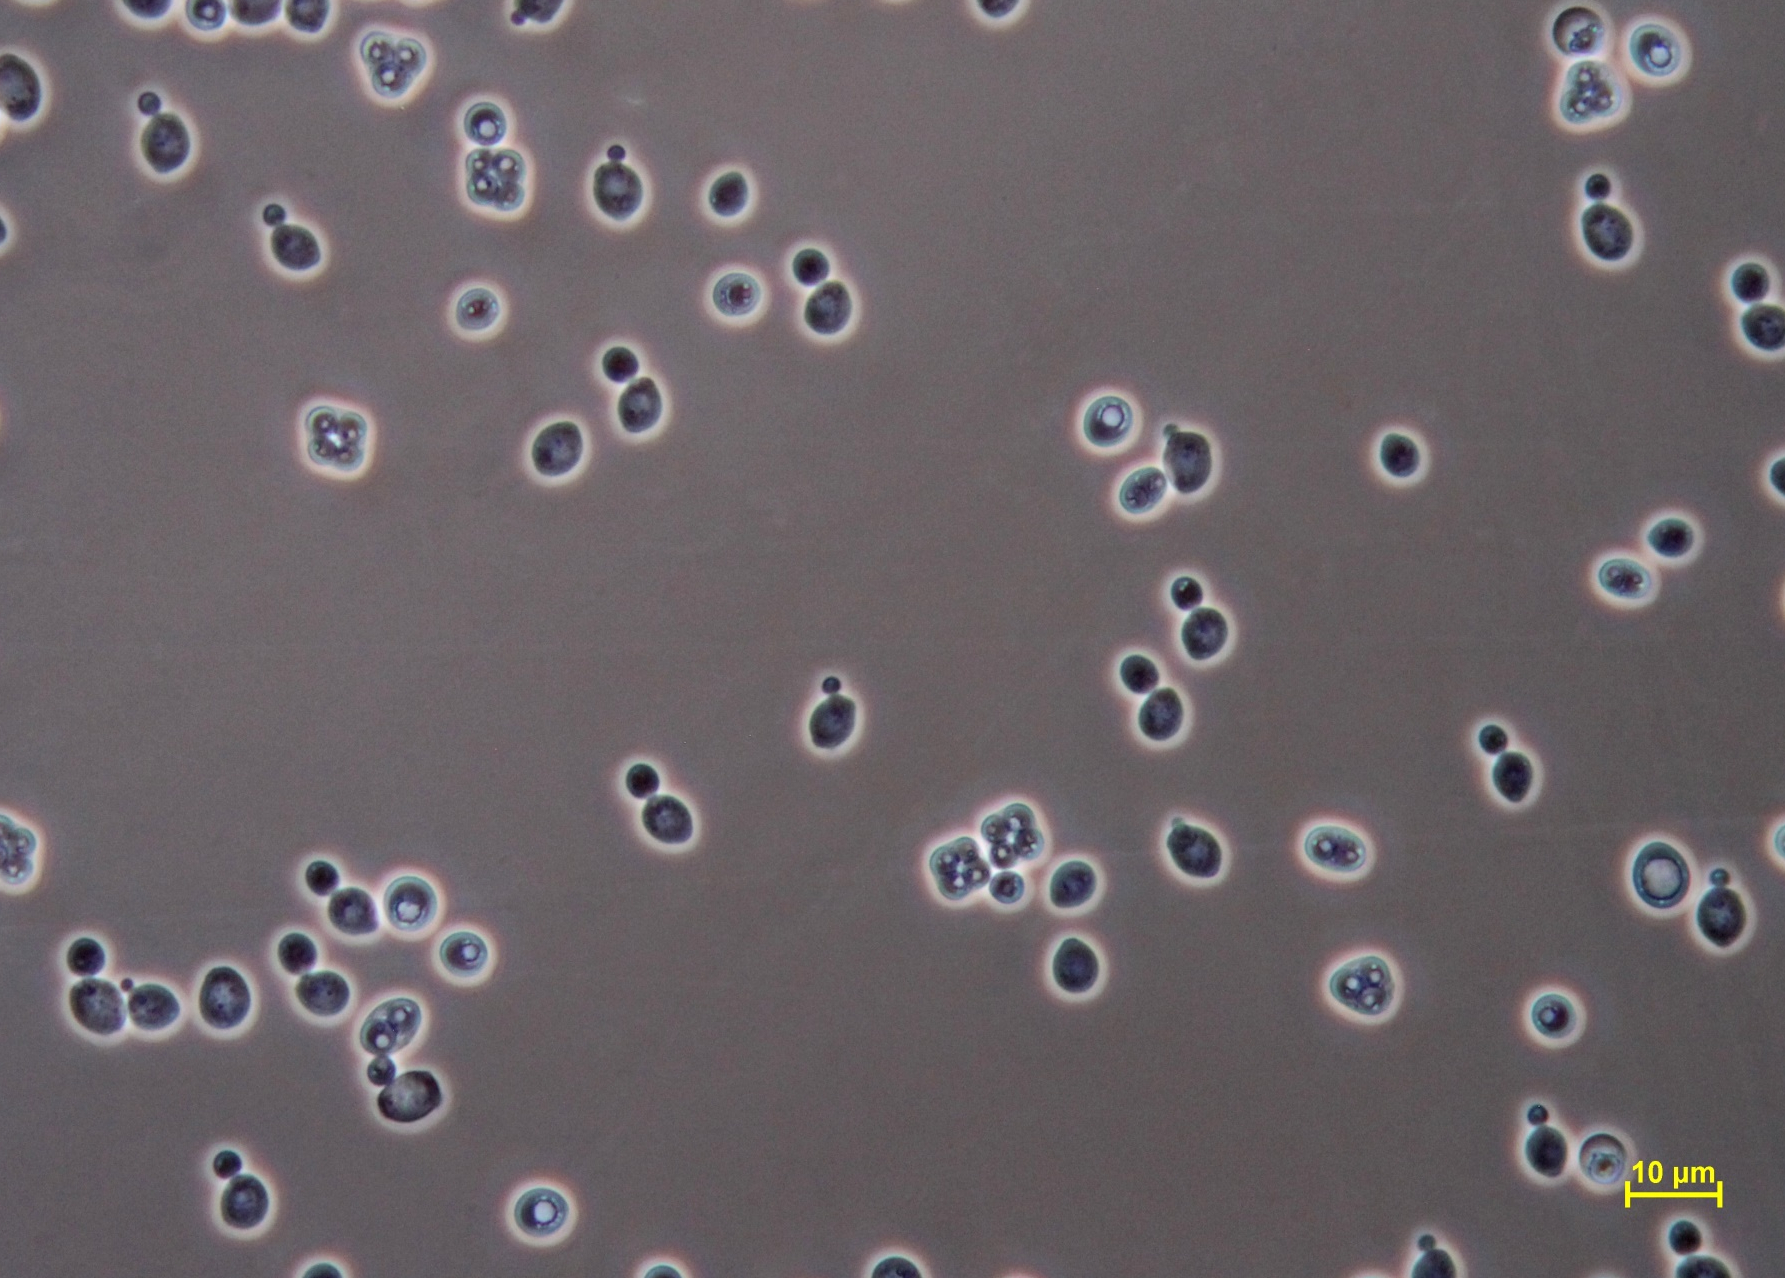
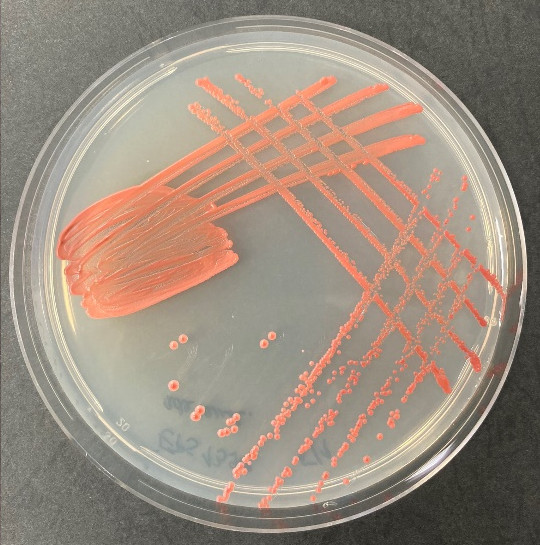
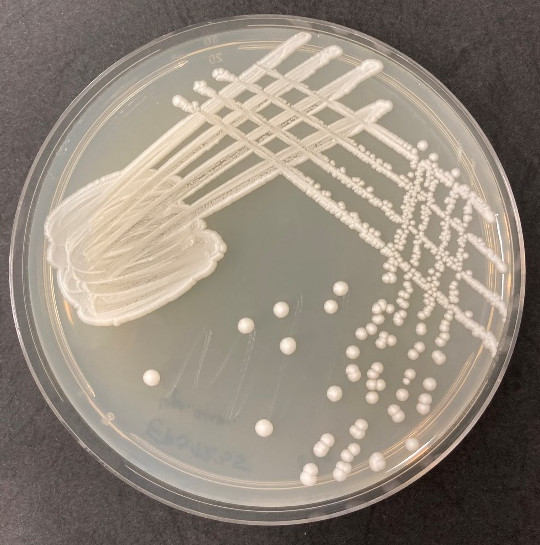

Projekt Vývoj sektových a hybridních vinařských kvasinek (NewSec) reflektuje na zvyšující se poptávku v enologické společnosti po sofistikovaných kvasinkových preparátech, které výrobku přinášejí přidanou hodnotu. Jednak je to využití autochtonních mikroorganismů a podpoření autentičnosti produktu (sektové kvasinky) a dále pak aplikovat nově vyšlechtěné hybridní kvasinky, které přináší řadu technologických výhod.
Náplň projektu je rozdělena do dvou podprojektových linií, jejichž společným jmenovatelem je skutečnost, že se jedná o kvasinkové preparáty určené pro enologickou aplikaci. Jsou to sektové kvasinky, které jsou určeny pro sekundární fermentaci v procesu výroby šumivých vín. V průběhu projektu bude připravena technologie selekce, charakterizace, kultivace a aplikace sektových kvasinek.
Druhá podprojektová linie řeší vývoj nových hybridních kvasinek vzniklých tzv. konvenčními metodami (nevznikne GMO). Při vývoji a selekci těchto kvasinek bude kladen důraz na vybrané fenotypové vlastnosti (obecně modulace senzorického projevu kvasinek - vyšší schopnost volatilizace monoterpenoidů, vyšší esterázová aktivita atd.). V rámci této linie vznikne technologický popis výběru vstupních kmenů, proces hybridizace a ověření jeho účinnosti, charakterizace hybridní populace, kultivace a jejich aplikace.
Projektové konsorcium tvoří společnost EPS biotechnology, s.r.o., která je etablovaným subjektem v oblasti vývoje a komercionalizace enologických preparátů. Partnerem z produkční sféry je Víno Hruška s.r.o., který se bude přímo podílet na vývoji za využití svých výrobních kapacit. Formou externí spolupráce je počítáno s dalším produkčním subjektem – Víno J. Stávek.